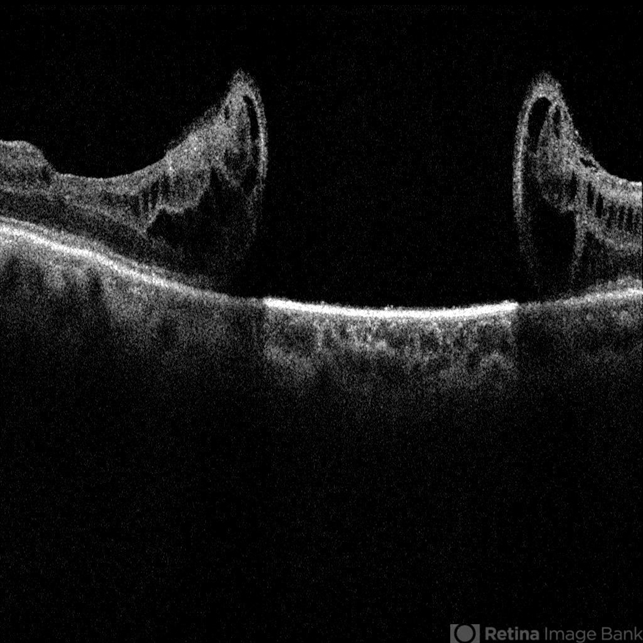

-
 By JEFFERSON R SOUSA, Tecg.º (Biomedical Systems Technology)
By JEFFERSON R SOUSA, Tecg.º (Biomedical Systems Technology)
Lens Oftalmologia - Hospital Beneficiência Portuguesa - Uploaded on Sep 10, 2017.
- Last modified by Caroline Bozell on Sep 11, 2017.
- Rating
- Appears in
- Miscellaneous
- Condition/keywords
- retinal hole
- Photographer
- JEFFERSON R SOUSA - Study Center and Ophthalmological Research Dr. Andre M V Gomes, Dr. Suel Abujamra Institute São Paulo-Brazil
- Imaging device
-
Optical coherence tomography system
OCT CIRRUS 4000, Protocol Horizontal line. - Description
- Patient 57-years-old, male, attended the clinic with complaint of low visual acuity and history of already having undergone a surgical procedure in another service. In previous evaluation of retinal mapping and retinography, being confirmed in optical coherence tomography, several retinal holes were observed in the posterior pole.

Initializing download.
Initializing download.








